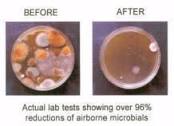

air purifiers for mold

Ultraviolet (UV) light is one form of electromagnetic energy produced naturally by the sun. UV is a spectrum of light just below the visible light and it is split into four distinct spectral areas – Vacuum UV (100 to 200 nm), UVC (200 to 280 nm), UVB (280 to 315 nm) and UVA (315 to 400 nm). What is Ultraviolet C?The entire UV spectrum can kill or inactivate many microorganism species, preventing them from replicating. UVC energy at 253.7 nanometres provides the most germicidal effect. The application of UVC energy to inactivate microorganisms is also known as Germicidal Irradiation or UVGI. UVC exposure inactivates microbial organisms such as bacteria and viruses by altering the structure and the molecular bonds of their DNA (Deoxyribonucleic acid). DNA is a “blue print” these organisms use to develop, function and reproduce. By destroying the organism’s ability to reproduce, it becomes harmless since it cannot colonize. After UVC exposure, the organism dies off leaving no offspring, and the population of the microorganism diminishes rapidly.

Ultraviolet germicidal lamps provide a much more powerful and concentrated effect of ultraviolet energy than can be found naturally. Germicidal UV provides a highly effective method of destroying microorganisms.
hunter air purifier red light It’s not just dirt – it’s biological.
air purifier australia where to buyWhat is HVAC biofilm?
best air purifier and humidifier in one Some people call it dirt. Some call it mud, slime or sludge. This gluey matrix growing on heating, ventilating and air conditioning (HVAC) evaporator coils, drain pans and ducts is, in fact, biofilm. Biofilm is an active, complex microbial matrix of mold and bacteria that adheres to the fins of the coil and protects the organisms from biocides.

The biofilms themselves give off products of metabolism known as volatile organic compounds (VOCs) which may range in effects from watery eyes and headaches, to more severe allergy and asthma responses. Numerous studies have demonstrated that the HVAC system is a viable amplifier, reservoir and disseminator of pathogenic and opportunistic bacteria, viruses and mold. The list below identifies some of the many microorganisms that have been isolated from evaporator coils, drain pans, ducts, final filters and diffusers. No matter how good the coil cleaner, sprayer or pressure washer used, the effectiveness of these methods reaches about 1 inch into the coil and the organic and biologically active matter gets packed deeper into the coil fins. Installed on air effluent side of the condensate cooling coils and the drain pan, Steril-Aire UVC energy destroys surface biofilm and airborne microorganisms before they circulate throughout the HVAC system. What are the most common biological contaminants found in air handling systems?

Numerous studies have demonstrated that the HVAC system is a viable reservoir of pathogenic and opportunistic bacteria and mold. Below is a partial list of microorganisms that have been found on evaporator coils, drain pans and ducts: How does HVAC biofilm impact indoor air quality? The quality of indoor air, influenced by the levels of bioaerosols, contaminants and pollutants, can affect occupant health and development, resulting in reduced productivity and increased absenteeism. The biofilms themselves give off products of metabolism known as volatile organic compounds (VOCs) which can trigger occupant complaints of watery eyes and headaches and even severe allergy and asthma responses. The biological contaminants typically found on HVAC coils and drain pans have also been linked to Sick Building Syndrome (SBS) and hospital acquired infections. How does HVAC biofilm impact HVAC energy use? Biological fouling of evaporator fin and tube heat exchangers is a key contributor to decreased HVAC capacity.

The biological fouling acts as an insulator, increasing air flow resistance and decreasing heat transfer. The fans run longer to maintain the building at the desired temperature, increasing kW draw with reduced cooling tonnage capacity. A mere 10% increase in fan motor run can significantly increase energy use. The chillers and pumps work harder to raise the leaving water temperature and achieve set temperature points. For each degree the water temperature is increased, a savings of 1-2% will be realized. Steril-Aire high output UVC provides continuous cleaning of coils, eliminating the biofilm that causes reductions in operational efficiency. Studies have shown that removal of a .024” layer of biofilm can reduce HVAC energy usage by 21% by restoring heat transfer and system efficiency. Reduced cooling coil pressure drop helps save fan energy, while improved cooling coil heat transfer efficiency. Higher chilled water temperature setpoints allows the chiller plant to operate more efficiently.

Read how Steril-Aire customers have improved system efficiency and achieved energy savings. Click here for our white paper “How Steril-Aire UVC Can Cut Energy and Operational Costs” How does UVC help conserve water? A 10,000 square foot building can produce more than 15,000 gallons of condensate water per year. Typically, this condensate is wasted and diverted to sewer systems. In order to effectively repurpose HVAC condensate, it must be free of biological components. Using Steril-Aire’s patented installation methodology and high output UVC directed at the cooling coil and drain pan, the condensate is distilled and clean. The condensate can be effectively collected for use as cooling tower makeup water or for gray water uses. Read how the University of Delaware has saved water and energy costs with Steril-Aire UVC. Click here for our white paper “UVC Saves HVAC Water, Energy and Chemical Use” How does UVC contribute to maintenance and operational savings?

Manual coil cleaning can be a major HVAC maintenance expense and may be very difficult to perform on small, tough-to-access packaged or unitary systems. Manually cleaning only temporarily removes the contaminants and in most cases, simply pushes the biological contaminants further back into the fins. Steril-Aire UVC solves these problems by eliminating the need for chemical cleaning or pressure washing of any size coil. It also eliminates the associated downtime and inconvenience. Maintenance crews and building occupants are no longer exposed to harmful cleaning chemicals and disinfectants. The surface cleaning effects of UVC helps restore older HVAC system to efficient operation and maintain new systems at factory design efficiency, while protecting system components against the acids that are emitted from the biofilm and the corrosive effects of chemical coil cleaning. How Does UVC for HVAC® Work?The C wavelength of the UV spectrum targets the DNA of microorganisms, destroying their cells and making replication impossible.

Directed at a cooling coil or drain pan, UVC energy destroys surface biofilm, a gluey matrix of microorganisms (bacteria, fungi, debris, et al.) that grows in the presence of moisture. Biofilm is prevalent in HVAC systems and leads to a host of indoor air quality (IAQ) and HVAC operational problems that are sometimes mistakenly attributed solely to mold. UVC also destroys airborne viruses and bacteria that circulate through an HVAC system. By applying the power of UVC at the source of contamination – the HVAC evaporator coils and drain pan – Steril-Aire UVC destroys the reservoir of microorganisms. Without the ability to reproduce, microorganisms become inactive and harmless. The recirculating air in HVAC systems creates redundancy in exposing microorganisms to UVC, ensuring multiple passes so the light energy is effective against large quantities of airborne microorganisms. Steril-Aire UVC delivers the highest UVC output, driving HVAC system efficiency while improving indoor air quality.

Watch our videos to learn more (Mold Wars/Ride the Green Wave) Where should UVC fixtures be installed?To keep coils clean and free of biofilm and other buildup, a high-output UVC-light source should be positioned perpendicular to the fins of the coil and 12 in. off the discharge coil face. When using high-output lamps to eliminate contamination from an existing system, a 24-in. centerline is recommended. With new systems, the centerline may extend to 30 in. Is UVC lamp output important?Output is critical because it affects a UVC lamp’s performance. To effectively clean coils and eliminate biofilm, a UVC device should provide output measure at a minimum of 9 µW/cm2 per inch of glass from a distance of 1 meter, when tested in a 400 fpm airstream at 50 °F. Steril-Aire has developed a UVC Application Standard that includes technical data and specifications, as well as installation, sizing, dosage and other guidelines to assist in the proper selection and application techniques of UVC lamp systems.
How do you know when to change the UVC Emitters? For large or critical applications, change out should be performed when Emitter output decreases by 40% as measured by a radiometer, after about 9,000 hours or 12 months. For installations with no radiometer, change Emitters annually (after about 9,000 hours). Does it produce ozone? No, Steril-Aire devices do not produce ozone or other secondary contaminants. According to the U.S. EPA, “Recovery from the harmful effects can occur following short-term exposure to low levels of ozone, but health effects may become more damaging and recovery less certain at higher levels or from longer exposures (US EPA, 1996a, 1996b).” How do you dispose of the used UVC Emitters? Dispose of them as you would any fluorescent tubes, in compliance with your country, local or state codes. What is the warranty? The UVC Emitters are warranted for 1 year (9,000 hours). Can UVC for HVAC contribute to LEED points?The use of Steril-Aire UVC may contribute to LEED points across multiple project types in one or more of the following areas: Energy and Atmosphere, Water Efficiency, Indoor Environmental Quality, Innovation & Design Process and Regional Priorities.